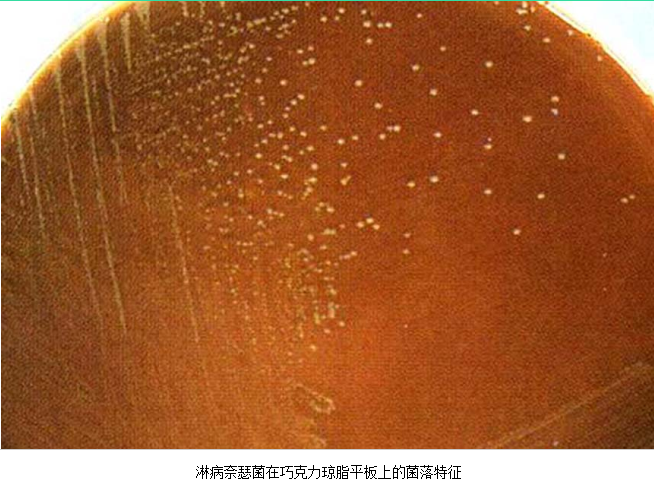
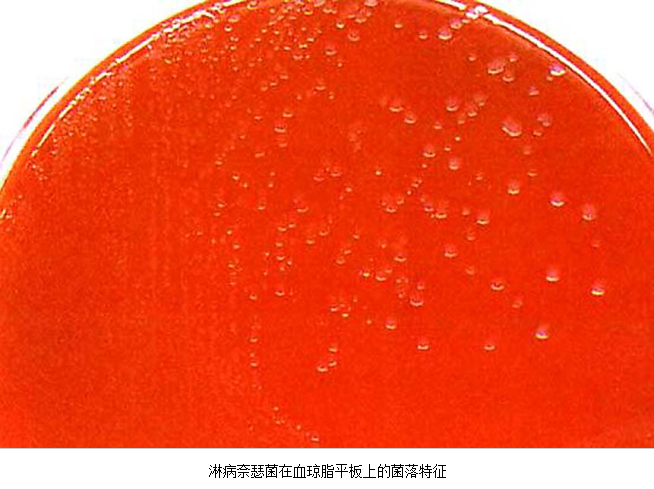

子宫颈炎症是妇科常见疾病之一,包括子宫颈阴道部炎症及子宫颈管黏膜炎症。因子宫颈阴道部鳞状上皮与阴道鳞状上皮相延续,阴道炎症均可引起子宫颈阴道部炎症。由于子宫颈管黏膜上皮为单层柱状上皮,抗感染能力较差,易发生感染。临床多见的子宫颈炎是急性子宫颈管黏膜炎,若急性子宫颈炎未经及时诊治或病原体持续存在,可导致慢性子宫颈炎症。
•病原体可为性传播疾病病原体或内源性病原体,但部分病原体不清。
•临床表现为阴道分泌物增多、经间期出血或伴泌尿系统感染等。
•子宫颈分泌物呈黏液脓性或棉拭子擦拭子宫颈管易诱发出血,分泌物镜检白细胞增多,可初步诊断。
•主要选择抗生素治疗,包括经验性和针对病原体的抗生素治疗。
急性子宫颈炎(acutecervicitis),指子宫颈发生急性炎症,包括局部充血、水肿,上皮变性、坏死,黏膜、黏膜下组织、腺体周围见大量中性粒细胞浸润,腺腔中可有脓性分泌物。急性子宫颈炎可由多种病原体引起,也可由物理因素、化学因素刺激或机械性子宫颈损伤、子宫颈异物伴发感染所致。
【病因及病原体】
急性子宫颈炎的病原体:①性传播疾病病原体:淋病奈瑟菌及沙眼衣原体,主要见于性传播疾病的高危人群;②内源性病原体:部分子宫颈炎的病原体与细菌性阴道病病原体、生殖支原体感染有关。但也有部分患者的病原体不清楚。沙眼衣原体及淋病奈瑟菌均感染子宫颈管柱状上皮,沿黏膜面扩散引起浅层感染,病变以子宫颈管明显。除子宫颈管柱状上皮外,淋病奈瑟菌还常侵袭尿道移行上皮、尿道旁腺及前庭大腺。






【临床表现】
大部分患者无症状。有症状者主要表现为阴道分泌物增多,呈黏液脓性,阴道分泌物刺激可引起外阴瘙痒及灼热感。此外,可出现经间期出血、性交后出血等症状。若合并尿路感染,可出现尿急、尿频、尿痛。妇科检查见子宫颈充血、水肿、黏膜外翻,有黏液脓性分泌物附着甚至从子宫颈管流出,子宫颈管黏膜质脆,容易诱发出血。若为淋病奈瑟菌感染,因尿道旁腺、前庭大腺受累,可见尿道口、阴道口黏膜充血、水肿以及多量脓性分泌物。

急性子宫颈炎黏液脓性分泌物
【诊断】
出现两个特征性体征之一、显微镜检查子宫颈或阴道分泌物白细胞增多,可做出急性子宫颈炎症的初步诊断。子宫颈炎症诊断后,需进一步做衣原体及淋病奈瑟菌的检测。
1.两个特征性体征,具备一个或两个同时具备:
(1)于子宫颈管或子宫颈管棉拭子标本上,肉眼见到脓性或黏液脓性分泌物。
(2)用棉拭子擦拭子宫颈管时,容易诱发子宫颈管内出血。


2.白细胞检测 子宫颈管分泌物或阴道分泌物中白细胞增多,后者需排除引起白细胞增多的阴道炎症。
(1)子宫颈管脓性分泌物涂片作革兰染色,中性粒细胞>30/高倍视野。
(2)阴道分泌物湿片检查白细胞>10/高倍视野。

急性子宫颈炎患者,子宫颈管脓性分泌物涂片作革兰氏染色,中性粒细胞>30/高倍视野,
箭头处为中性粒细胞内可见革兰氏阴性双球菌

3.病原体检测 应作衣原体及淋病奈瑟菌的检测,以及有无细菌性阴道病及滴虫阴道炎。检测淋病奈瑟菌常用的方法有:①分泌物涂片革兰染色,查找中性粒细胞内有无革兰阴性双球菌,由于子宫颈分泌物的敏感性、特异性差,不推荐用于女性淋病的诊断方法。②淋病奈瑟菌培养,为诊断淋病的金标准方法。③核酸检测,包括核酸杂交及核酸扩增,尤其核酸扩增方法诊断淋病奈瑟菌感染的敏感性及特异性高。检测沙眼衣原体常用的方法有:①衣原体培养,因其方法复杂,临床少用。②酶联免疫吸附试验检测沙眼衣原体抗原,为临床常用的方法。③核酸检测,包括核酸杂交及核酸扩增,尤以后者为检测衣原体感染敏感、特异的方法。但应做好质量控制,避免污染。
若子宫颈炎症进一步加重,可导致上行感染,因此对子宫颈炎症患者应注意有无上生殖道感染。

【治疗】
主要为抗生素药物治疗。可根据不同情况采用经验性抗生素治疗及针对病原体的抗生素治疗。
1.经验性抗生素治疗 对有以下性传播疾病高危因素的患者(如年龄小于25岁,多性伴或新性伴,并且为无保护性性交),在未获得病原体检测结果前,采用针对衣原体的经验性抗生素治疗,方案为阿奇霉素1g单次顿服;或多西环素100mg,每日2次,连服7日。
2.针对病原体的抗生素治疗 对于获得病原体者,选择针对病原体的抗生素。
(1)单纯急性淋病奈瑟菌性子宫颈炎:主张大剂量、单次给药,常用药物有头孢菌素,如头孢曲松钠250mg,单次肌内注射;或头孢克肟400mg,单次口服;也可选择头孢唑肟500mg,肌内注射;头孢西丁2g,肌内注射,加用丙磺舒1g口服;头孢噻肟钠500mg,肌内注射;另可选择氨基糖苷类抗生素中的大观霉素4g,单次肌内注射。
(2)沙眼衣原体感染所致子宫颈炎:治疗药物主要有:①四环素类:如多西环素100mg,每日2次,连服7日;②红霉素类:主要有阿奇霉素1g,单次顿服,或红霉素500mg,每日4次,连服7日;③喹诺酮类:主要有氧氟沙星300mg,每日2次,连服7日;左氧氟沙星500mg,每日1次,连服7日;莫西沙星400mg,每日1次,连服7日。
由于淋病奈瑟菌感染常伴有衣原体感染,因此,若为淋菌性子宫颈炎,治疗时除选用抗淋病奈瑟菌药物外,同时应用抗衣原体感染药物。
(3)合并细菌性阴道病:同时治疗细菌性阴道病,否则将导致子宫颈炎持续存在。
3.性伴侣的处理 若子宫颈炎患者的病原体为沙眼衣原体及淋病奈瑟菌,应对其性伴进行相应的检查及治疗。


